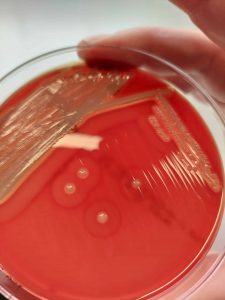

Latest News – The Horse

Help, My Horses Won’t Eat Their Hay
A nutritionist gives different reasons why two horses might not be consuming enough hay.

The Scoop on Loose Poop: Equine Diarrhea
Diarrhea in adult horses can be life-threatening, so it is important for horse owners to know when to call their veterinarian and when to wait.

Select Higher Frequency Ultrasound Transducers for Sesamoidean Ligaments
A higher-frequency transducer increased diagnostic accuracy for both suspensory ligament branches and distal sesamoidean ligaments.

Special Report: 2022 AAEP Vet Wellness Coverage
Learn about equine veterinarian wellness, boundary-setting, and shifting vet-client relationship paradigms in this compilation of articles brought to you by Sentinel Horse Feeds.

EIA Confirmed in California Mule
The mule resides in Fresno County, where six other equids are exposed.

Building A Team-Based Culture in Equine Practice
One veterinarian says team-based culture promotes practice efficiency and creativity and, ultimately, profitability.

How Equine Vets Can Manage Difficult Client Situations
One veterinarian offers advice for building client relationships and dealing with difficult situations in equine practice.

Strangles Confirmed in Ontario Quarter Horse
The mare resides at a boarding facility in Lanark County.
S. Aureus a Contributing Factor in Equine Pastern Dermatitis
Equine pastern dermatitis is a potentially painful condition that can spread between horses if not treated properly.

Back From the Brink: Refeeding Malnourished Horses
Meet 3 horses successfully rehabilitated after being malnourished, and learn about the efforts made to save them from neglect.

California EHM Outbreak: 600 Horses Quarantined
Two polo horses in Riverside County are positive for EHM, and the 600 horses at the polo facility are under mandatory quarantine.

Boots and Wraps for Scratches Prevention
Boots and wraps might help prevent scratches, but only when used properly and with other management techniques.

Neurologic Herpesvirus in Three Colorado Horses
The horses reside in Pueblo County and are under official quarantine.

Researchers Unraveling the Mysteries of Recurrent Colic
Find out how veterinarians prevent and treat this painful condition.

Strangles Confirmed in Ontario Mare
The mare resides at a boarding facility in Wellington County.

Scratches Awareness Week Sponsored by Phovia Equine
Look for educational information about scratches in horses on TheHorse.com.











